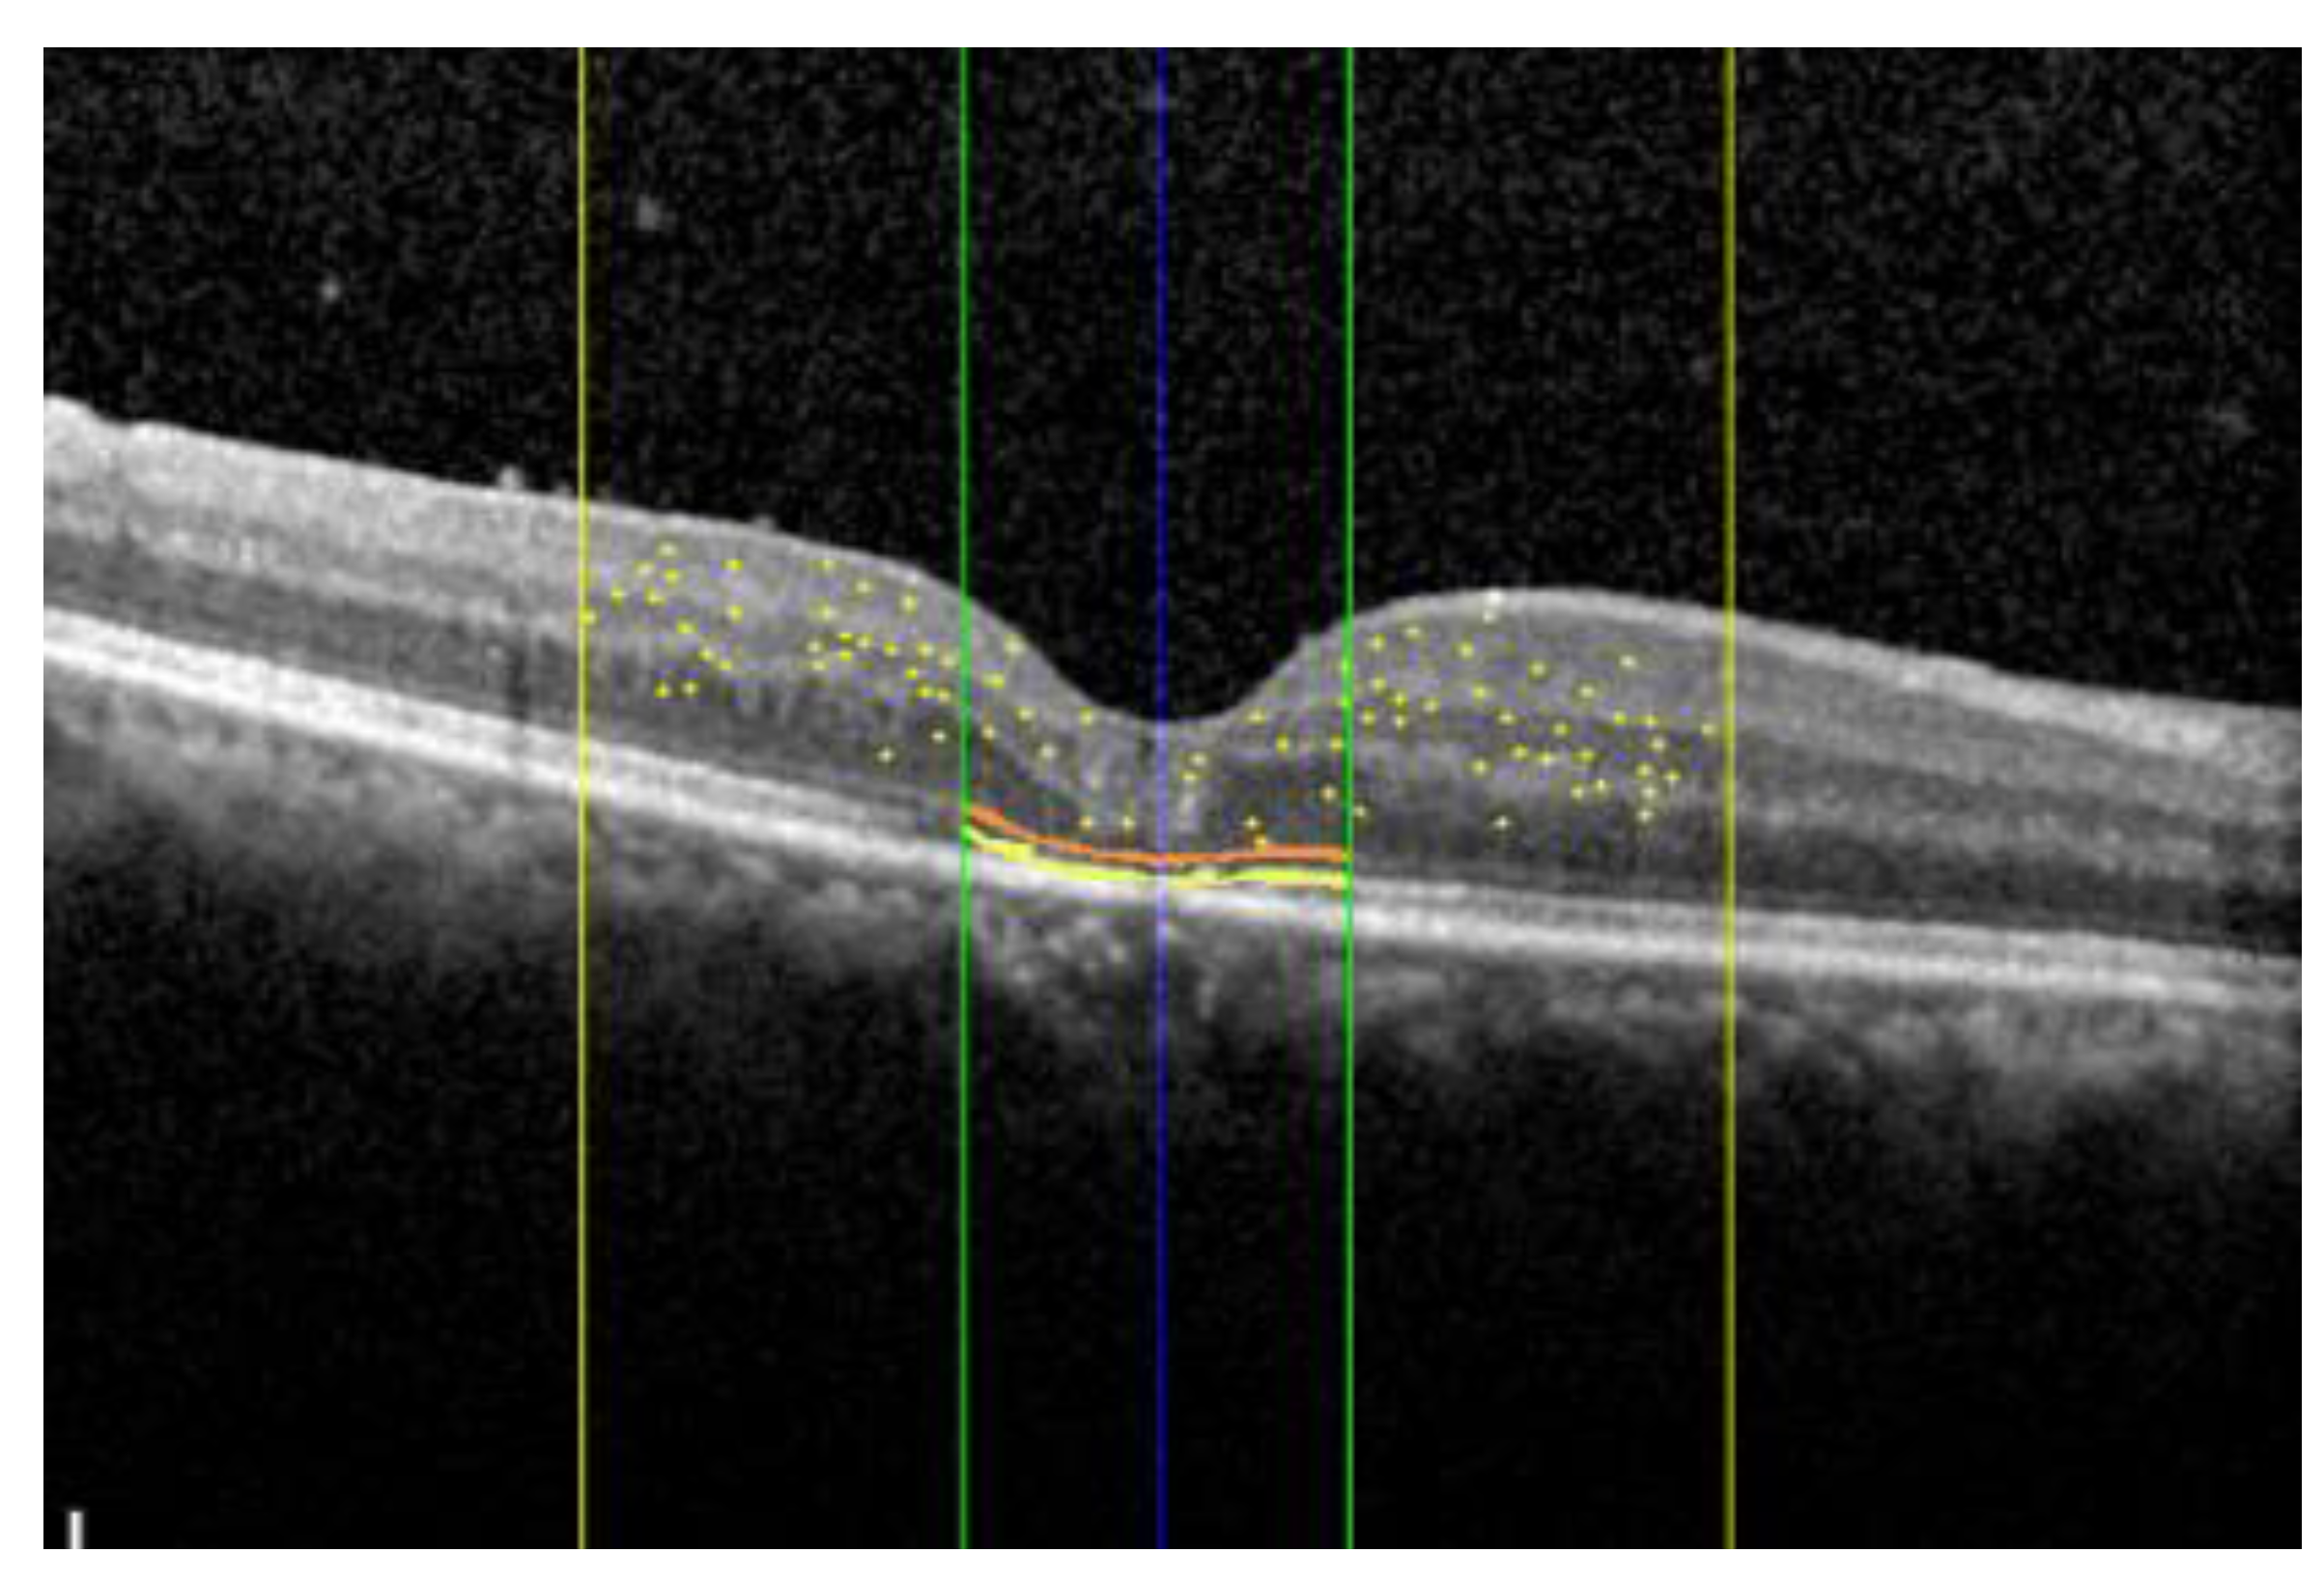
Jcm 13 00628 g001b

Novel Artificial Intelligence-Based Assessment of Imaging Biomarkers in Full-Thickness Macular Holes: Preliminary Data from a Pivotal Trial
Abstract
1. Introduction
2. Materials and Methods
2.1. Study Design and Dataset
2.2. AI Algorithm Description and Analysis
2.3. Retinal Biomarker Evaluation
2.4. Statistical Analysis
3. Results
4. Discussion
5. Conclusions
Author Contributions
Funding
Institutional Review Board Statement
Informed Consent Statement
Data Availability Statement
Conflicts of Interest
References
- Chen, Q.; Liu, Z.-X. Idiopathic Macular Hole: A Comprehensive Review of Its Pathogenesis and of Advanced Studies on Metamorphopsia. J. Ophthalmol. 2019, 2019, 7294952. [Google Scholar] [CrossRef] [PubMed]
- Gass, J.D. Idiopathic Senile Macular Hole. Its Early Stages and Pathogenesis. Arch. Ophthalmol. 1988, 106, 629–639. [Google Scholar] [CrossRef] [PubMed]
- Ittarat, M.; Somkijrungroj, T.; Chansangpetch, S.; Pongsachareonnont, P. Literature Review of Surgical Treatment in Idiopathic Full-Thickness Macular Hole. Clin. Ophthalmol. 2020, 14, 2171–2183. [Google Scholar] [CrossRef]
- Pradhan, D.; Agarwal, L.; Joshi, I.; Kushwaha, A.; Aditya, K.; Kumari, A. Internal Limiting Membrane Peeling in Macular Hole Surgery. Ger. Med. Sci. 2022, 20, Doc07. [Google Scholar] [PubMed]
- Scott, I.U.; Moraczewski, A.L.; Smiddy, W.E.; Flynn, H.W., Jr.; Feuer, W.J. Long-Term Anatomic and Visual Acuity Outcomes after Initial Anatomic Success with Macular Hole Surgery. Am. J. Ophthalmol. 2003, 135, 633–640. [Google Scholar] [CrossRef]
- Fallico, M.; Jackson, T.L.; Chronopoulos, A.; Hattenbach, L.-O.; Longo, A.; Bonfiglio, V.; Russo, A.; Avitabile, T.; Parisi, F.; Romano, M.; et al. Factors Predicting Normal Visual Acuity Following Anatomically Successful Macular Hole Surgery. Acta Ophthalmol. 2021, 99, e324–e329. [Google Scholar] [CrossRef] [PubMed]
- Duker, J.S.; Kaiser, P.K.; Binder, S.; de Smet, M.D.; Gaudric, A.; Reichel, E.; Sadda, S.R.; Sebag, J.; Spaide, R.F.; Stalmans, P. The International Vitreomacular Traction Study Group Classification of Vitreomacular Adhesion, Traction, and Macular Hole. Ophthalmology 2013, 120, 2611–2619. [Google Scholar] [CrossRef]
- Schmidt-Erfurth, U.; Sadeghipour, A.; Gerendas, B.S.; Waldstein, S.M.; Bogunović, H. Artificial Intelligence in Retina. Prog. Retin. Eye Res. 2018, 67, 1–29. [Google Scholar] [CrossRef]
- Chakroborty, S.; Gupta, M.; Devishamani, C.S.; Patel, K.; Ankit, C.; Ganesh Babu, T.C.; Raman, R. Narrative Review of Artificial Intelligence in Diabetic Macular Edema: Diagnosis and Predicting Treatment Response Using Optical Coherence Tomography. Indian J. Ophthalmol. 2021, 69, 2999–3008. [Google Scholar]
- Shahriari, M.H.; Sabbaghi, H.; Asadi, F.; Hosseini, A.; Khorrami, Z. Artificial Intelligence in Screening, Diagnosis, and Classification of Diabetic Macular Edema: A Systematic Review. Surv. Ophthalmol. 2023, 68, 42–53. [Google Scholar] [CrossRef]
- Schlegl, T.; Waldstein, S.M.; Bogunovic, H.; Endstraßer, F.; Sadeghipour, A.; Philip, A.-M.; Podkowinski, D.; Gerendas, B.S.; Langs, G.; Schmidt-Erfurth, U. Fully Automated Detection and Quantification of Macular Fluid in OCT Using Deep Learning. Ophthalmology 2018, 125, 549–558. [Google Scholar] [CrossRef] [PubMed]
- Habra, O.; Gallardo, M.; Meyer Zu Westram, T.; De Zanet, S.; Jaggi, D.; Zinkernagel, M.; Wolf, S.; Sznitman, R. Evaluation of an Artificial Intelligence-Based Detector of Sub- and Intraretinal Fluid on a Large Set of Optical Coherence Tomography Volumes in Age-Related Macular Degeneration and Diabetic Macular Edema. Ophthalmologica 2022, 245, 516–527. [Google Scholar] [CrossRef] [PubMed]
- Roberts, P.K.; Vogl, W.-D.; Gerendas, B.S.; Glassman, A.R.; Bogunovic, H.; Jampol, L.M.; Schmidt-Erfurth, U.M. Quantification of Fluid Resolution and Visual Acuity Gain in Patients with Diabetic Macular Edema Using Deep Learning: A Post Hoc Analysis of a Randomized Clinical Trial. JAMA Ophthalmol. 2020, 138, 945–953. [Google Scholar] [CrossRef] [PubMed]
- Gerendas, B.S.; Sadeghipour, A.; Michl, M.; Goldbach, F.; Mylonas, G.; Gruber, A.; Alten, T.; Leingang, O.; Sacu, S.; Bogunovic, H.; et al. Validation of an Automated Fluid Algorithm on Real-World Data of Neovascular Age-Related Macular Degeneration over Five Years. Retina 2022, 42, 1673–1682. [Google Scholar] [CrossRef] [PubMed]
- de Smet, M.D.; Julian, K.; Maurin, J.; Jolissaint, L.P.; Mura, M. Retinal Relaxation Following Membrane Peeling: Effect on Vision, Central Macular Thickness, and Vector Analysis of Motion. J. Clin. Transl. Res. 2020, 5, 236–242. [Google Scholar] [CrossRef] [PubMed]
- Jiang, T.; Gradus, J.L.; Rosellini, A.J. Supervised Machine Learning: A Brief Primer. Behav. Ther. 2020, 51, 675–687. [Google Scholar] [CrossRef] [PubMed]
- Midena, E.; Toto, L.; Frizziero, L.; Covello, G.; Torresin, T.; Midena, G.; Danieli, L.; Pilotto, E.; Figus, M.; Mariotti, C.; et al. Validation of an Automated Artificial Intelligence Algorithm for the Quantification of Major OCT Parameters in Diabetic Macular Edema. J. Clin. Med. 2023, 12, 2134. [Google Scholar] [CrossRef]
- Fiore, T.; Androudi, S.; Iaccheri, B.; Lupidi, M.; Giansanti, F.; Fruttini, D.; Biondi, L.; Cagini, C. Repeatability and Reproducibility of Retinal Thickness Measurements in Diabetic Patients with Spectral Domain Optical Coherence Tomography. Curr. Eye Res. 2013, 38, 674–679. [Google Scholar] [CrossRef]
- Obata, S.; Ichiyama, Y.; Kakinoki, M.; Sawada, O.; Saishin, Y.; Ito, T.; Tomioka, M.; Ohji, M. Prediction of Postoperative Visual Acuity after Vitrectomy for Macular Hole Using Deep Learning-Based Artificial Intelligence. Graefes Arch. Clin. Exp. Ophthalmol. 2022, 260, 1113–1123. [Google Scholar] [CrossRef]
- Xiao, Y.; Hu, Y.; Quan, W.; Zhang, B.; Wu, Y.; Wu, Q.; Liu, B.; Zeng, X.; Lin, Z.; Fang, Y.; et al. Machine Learning-Based Prediction of Anatomical Outcome after Idiopathic Macular Hole Surgery. Ann. Transl. Med. 2021, 9, 830. [Google Scholar] [CrossRef]
- Zgolli, H.; El Zarrug, H.H.K.; Meddeb, M.; Mabrouk, S.; Khlifa, N. Anatomical Prognosis after Idiopathic Macular Hole Surgery: Machine Learning Based-Predection. Libyan J. Med. 2022, 17, 2034334. [Google Scholar] [CrossRef] [PubMed]
- Xiao, Y.; Hu, Y.; Quan, W.; Yang, Y.; Lai, W.; Wang, X.; Zhang, X.; Zhang, B.; Wu, Y.; Wu, Q.; et al. Development and Validation of a Deep Learning System to Classify Aetiology and Predict Anatomical Outcomes of Macular Hole. Br. J. Ophthalmol. 2023, 107, 109–115. [Google Scholar] [CrossRef] [PubMed]
- Inoda, S.; Takahashi, H.; Arai, Y.; Tampo, H.; Matsui, Y.; Kawashima, H.; Yanagi, Y. An AI Model to Estimate Visual Acuity Based Solely on Cross-Sectional OCT Imaging of Various Diseases. Graefes Arch. Clin. Exp. Ophthalmol. 2023, 261, 2775–2785. [Google Scholar] [CrossRef] [PubMed]
- Morawski, K.; Jędrychowska-Jamborska, J.; Kubicka-Trząska, A.; Romanowska-Dixon, B. The Analysis of Spontaneous Closure Mechanisms and Regeneration of Retinal Layers of a Full-Thickness Macular Hole. Retina 2016, 36, 2132–2139. [Google Scholar] [CrossRef] [PubMed]
- Landa, G.; Gentile, R.C.; Garcia, P.M.T.; Muldoon, T.O.; Rosen, R.B. External Limiting Membrane and Visual Outcome in Macular Hole Repair: Spectral Domain OCT Analysis. Eye 2012, 26, 61–69. [Google Scholar] [CrossRef] [PubMed]
- Ruiz-Moreno, J.M.; Lugo, F.; Montero, J.A.; Piñero, D.P. Restoration of Macular Structure as the Determining Factor for Macular Hole Surgery Outcome. Graefes Arch. Clin. Exp. Ophthalmol. 2012, 250, 1409–1414. [Google Scholar] [CrossRef]
- Funata, M.; Wendel, R.T.; de la Cruz, Z.; Green, W.R. Clinicopathologic Study of Bilateral Macular Holes Treated with Pars Plana Vitrectomy and Gas Tamponade. Retina 1992, 12, 289–298. [Google Scholar] [CrossRef]
- Frangieh, G.T.; Green, W.R.; Engel, H.M. A Histopathologic Study of Macular Cysts and Holes. Retina 1981, 1, 311–336. [Google Scholar] [CrossRef]
- Bolz, M.; Schmidt-Erfurth, U.; Deak, G.; Mylonas, G.; Kriechbaum, K.; Scholda, C.; Diabetic Retinopathy Research Group Vienna. Optical Coherence Tomographic Hyperreflective Foci: A Morphologic Sign of Lipid Extravasation in Diabetic Macular Edema. Ophthalmology 2009, 116, 914–920. [Google Scholar] [CrossRef]
- Fragiotta, S.; Abdolrahimzadeh, S.; Dolz-Marco, R.; Sakurada, Y.; Gal-Or, O.; Scuderi, G. Significance of Hyperreflective Foci as an Optical Coherence Tomography Biomarker in Retinal Diseases: Characterization and Clinical Implications. J. Ophthalmol. 2021, 2021, 6096017. [Google Scholar] [CrossRef]
- Brockmann, T.; Steger, C.; Weger, M.; Wedrich, A.; Haas, A. Risk Assessment of Idiopathic Macular Holes Undergoing Vitrectomy with Dye-Assisted Internal Limiting Membrane Peeling. Retina 2013, 33, 1132–1136. [Google Scholar] [CrossRef] [PubMed]
- Chhablani, J.; Khodani, M.; Hussein, A.; Bondalapati, S.; Rao, H.B.; Narayanan, R.; Sudhalkar, A. Role of Macular Hole Angle in Macular Hole Closure. Br. J. Ophthalmol. 2015, 99, 1634–1638. [Google Scholar] [CrossRef] [PubMed]
- Goto, K.; Iwase, T.; Yamamoto, K.; Ra, E.; Terasaki, H. Correlations between Intraretinal Cystoid Cavities and Pre- and Postoperative Characteristics of Eyes after Closure of Idiopathic Macular Hole. Sci. Rep. 2020, 10, 2310. [Google Scholar] [CrossRef] [PubMed]
- Sugiura, Y.; Okamoto, F.; Okamoto, Y.; Hiraoka, T.; Oshika, T. Relationship between Metamorphopsia and Intraretinal Cysts within the Fluid Cuff after Surgery for Idiopathic Macular Hole. Retina 2017, 37, 70–75. [Google Scholar] [CrossRef] [PubMed]
- Joo, J.-H.; Nam, W.H.; Joo, T.; Moon, S.W. Role of Intraretinal Cysts in the Prediction of Postoperative Closure and Photoreceptor Damages of the Idiopathic Full-Thickness Macular Hole. BMC Ophthalmol. 2022, 22, 5. [Google Scholar] [CrossRef]
- Ozturk, Y.; Ağın, A.; Kockar, N.; Ay, N.; Imamoglu, S.; Ozcelik Kose, A.; Kugu, S. The Importance of Anatomic Configuration and Cystic Changes in Macular Hole: Predicting Surgical Success with a Different Approach. Curr. Eye Res. 2022, 47, 1436–1443. [Google Scholar] [CrossRef]
- Nair, U.; Sheth, J.U.; Indurkar, A.; Soman, M. Intraretinal Cysts in Macular Hole: A Structure-Function Correlation Based on En Face Imaging. Clin. Ophthalmol. 2021, 15, 2953–2962. [Google Scholar] [CrossRef]
- Ruiz-Moreno, J.M.; Staicu, C.; Piñero, D.P.; Montero, J.; Lugo, F.; Amat, P. Optical Coherence Tomography Predictive Factors for Macular Hole Surgery Outcome. Br. J. Ophthalmol. 2008, 92, 640–644. [Google Scholar] [CrossRef]
- Shimozono, M.; Oishi, A.; Hata, M.; Kurimoto, Y. Restoration of the Photoreceptor Outer Segment and Visual Outcomes after Macular Hole Closure: Spectral-Domain Optical Coherence Tomography Analysis. Graefes Arch. Clin. Exp. Ophthalmol. 2011, 249, 1469–1476. [Google Scholar] [CrossRef]
- Itoh, Y.; Inoue, M.; Rii, T.; Hiraoka, T.; Hirakata, A. Correlation between Length of Foveal Cone Outer Segment Tips Line Defect and Visual Acuity after Macular Hole Closure. Ophthalmology 2012, 119, 1438–1446. [Google Scholar] [CrossRef]
- Govetto, A.; Bacherini, D.; Romano, M.R.; Matteucci, M.; Lucchini, S.; Cifarelli, L.; Dragotto, F.; Cereda, M.; Parrulli, S.; Staurenghi, G.; et al. Full-Thickness Macular Hole: Are Supra-RPE Granular Deposits Remnants of Photoreceptors Outer Segments? Clinical Implications. Am. J. Ophthalmol. 2023, 245, 86–101. [Google Scholar] [CrossRef] [PubMed]

| Eyes (n) | 20 |
| Age (years) | 63.3 ± 13.24 |
| Female/Male n(%) | 9 (45%)/11 (55%) |
| Right Eye/Left Eye n (%) | 10 (50%)/10 (50%) |
| Mean FTMH Size/Diameter (μm) | 285.36 ± 97.4 |
| Preoperative | Postoperative | p-Value | |||||
|---|---|---|---|---|---|---|---|
| Mean | SD | Median (Q1–Q3) | Mean | SD | Median (Q1–Q3) | ||
| BCVA (logMAR) | 0.76 | 0.16 | 0.7 (0.7–0.82) | 0.38 | 0.16 | 0.38 (0.29–0.52) | 0.001 |
| Visual Recovery (logMAR) | / | / | / | 0.37 | 0.16 | 0.36 (0.29–0.44) | N/A |
| IRF Volume (mm3) | 0.58 | 0.63 | 0.35 (0.18–0.60) | 0.01 | 0.01 | 0.01 (0.01–0.02) | 0.0001 |
| SRF Volume (mm3) | / | / | / | 0.01 | 0.01 | 0.01 (0–0.01) | N/A |
| ELM Interruption (%) | 79 | 18 | 82 (69–94) | 34 | 37 | 12 (0–70) | 0.0006 |
| EZ Interruption (%) | 80 | 22 | 77 (60–99) | 40 | 36 | 46 (17–94) | 0.0007 |
| HRF [3 mm] | 60.86 | 21.02 | 66.5 (49–77.3) | 60.79 | 33.34 | 71 (44–84.5) | 0.9999 |
| Parameters Correlated | R | p |
|---|---|---|
| Preop IRF–Visual Recovery | −0.50 | 0.026 |
| % ELM Interruption–Visual Recovery | −0.50 | 0.026 |
| % EZ Interruption–Visual Recovery | −0.53 | 0.017 |
| Postop SRF–Visual Recovery | 0.05 | 0.836 |
Disclaimer/Publisher’s Note: The statements, opinions and data contained in all publications are solely those of the individual author(s) and contributor(s) and not of MDPI and/or the editor(s). MDPI and/or the editor(s) disclaim responsibility for any injury to people or property resulting from any ideas, methods, instructions or products referred to in the content. |
© 2024 by the authors. Licensee MDPI, Basel, Switzerland. This article is an open access article distributed under the terms and conditions of the Creative Commons Attribution (CC BY) license (https://creativecommons.org/licenses/by/4.0/).
Share and Cite
Mariotti, C.; Mangoni, L.; Iorio, S.; Lombardo, V.; Fruttini, D.; Rizzo, C.; Chhablani, J.; Midena, E.; Lupidi, M. Novel Artificial Intelligence-Based Assessment of Imaging Biomarkers in Full-Thickness Macular Holes: Preliminary Data from a Pivotal Trial. J. Clin. Med. 2024, 13, 628. https://doi.org/10.3390/jcm13020628
Mariotti C, Mangoni L, Iorio S, Lombardo V, Fruttini D, Rizzo C, Chhablani J, Midena E, Lupidi M. Novel Artificial Intelligence-Based Assessment of Imaging Biomarkers in Full-Thickness Macular Holes: Preliminary Data from a Pivotal Trial. Journal of Clinical Medicine. 2024; 13(2):628. https://doi.org/10.3390/jcm13020628
Chicago/Turabian StyleMariotti, Cesare, Lorenzo Mangoni, Silvia Iorio, Veronica Lombardo, Daniela Fruttini, Clara Rizzo, Jay Chhablani, Edoardo Midena, and Marco Lupidi. 2024. "Novel Artificial Intelligence-Based Assessment of Imaging Biomarkers in Full-Thickness Macular Holes: Preliminary Data from a Pivotal Trial" Journal of Clinical Medicine 13, no. 2: 628. https://doi.org/10.3390/jcm13020628
APA StyleMariotti, C., Mangoni, L., Iorio, S., Lombardo, V., Fruttini, D., Rizzo, C., Chhablani, J., Midena, E., & Lupidi, M. (2024). Novel Artificial Intelligence-Based Assessment of Imaging Biomarkers in Full-Thickness Macular Holes: Preliminary Data from a Pivotal Trial. Journal of Clinical Medicine, 13(2), 628. https://doi.org/10.3390/jcm13020628

